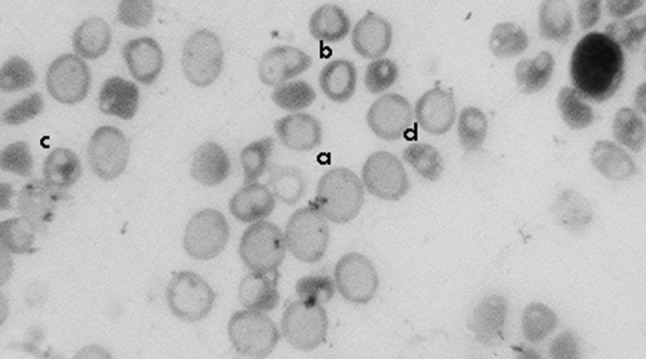
Fig. 1
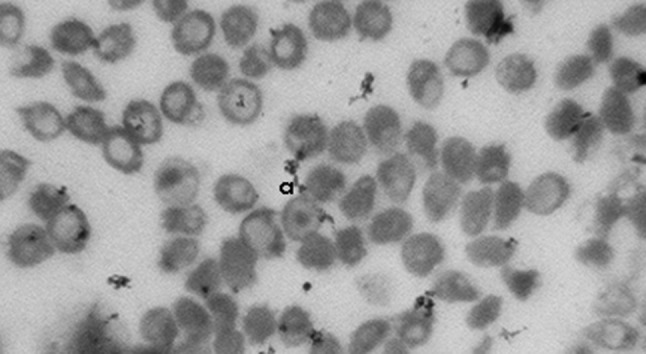
Fig. 3

Abstract
New Zealand white rabbits (N = 4) were challenged with the local strain of Trypanosoma evansi. Each rabbit was infected with 5 × 105 trypanosomes subcutaneously. The infection was characterized by intermittent pyrexia, undulating parasitaemia, anorexia and emaciation. The infected rabbits were examined daily for development of clinical signs and infection status by wet blood-films made from the ear veins. Thick and thin blood smears were also examined daily until the end of the experiment for description of blood cells. Differential leukocyte count (DLC) was also done. The parasite was observed in the blood during the acute phase only. Leukocytosis in the acute phase followed by leukopenia during the chronic phase was recognized. Haematological studies revealed reduced TEC, Hb and PCV. The main changes in the erythrocytes were macrocytes, hypochromic cells, Howell–Jolly bodies, target cells, stomatocytes and burr cells. Serum chemistry revealed hypoproteinemia, hypocholesterolaemia, hypoglycemia, hyperbilirubinemia, elevated creatinine, BUN, increased AST and ALT.
Keywords: Rabbits, Haemato-biochemical changes, Trypanosoma evansi
Introduction
Trypanosoma evansi causes a disease known as ‘surra’ in numerous mammalian hosts. The incidence and the severity of the disease vary with the strain of the parasite as well as the species of host affected. In Indian subcontinent, the disease is a constant threat to livestock productivity. Although haemato-biochemical changes of the disease by different species of trypanosomes in domestic and laboratory animals has been well documented (Takeet and Fagbemi 2009), yet the information on haemato-biochemical changes in rabbits induced by T. evansi is meager. Hence, the present investigation was intended to study haemato-biochemical changes in rabbits induced by local isolate of T. evansi.
Materials and methods
The virulent strain of T. evansi was isolated from a cattle suffering from clinical surra. The strain was maintained in vivo in whistar rats through serial passages. The blood of infected rats was collected by tail clipping and examined daily from the second day of post-inoculation. The infected rats with high parasitaemia were anaesthetized with thiopental sodium and blood was collected directly from the heart in vials containing heparin @ 30 I.U. per ml of blood. Six New Zealand white rabbits were maintained in fly proof house with clean and hygienic environment throughout the experimental period for 12 weeks by taking necessary precautions. Rabbits were kept on adlibitum feed and boiled filtered water was provided to these animals throughout the experimental study. The experimental rabbits were tested for gastrointestinal and blood parasites and were treated with fenbendazole and ivermectin at the rate of 5 mg/kg body weight and 200 µg/kg body weight respectively (Takeet and Fagbemi 2009). The rabbits were randomly assigned into two groups: one included four animals (infected group), the other two were in control group. Each animal was infected with 5 × 105 trypanosomes subcutaneously. The animals were examined daily for development of clinical signs and the infection status was confirmed by the examination of wet blood-films made from the ear veins.
Blood collected in 10 % EDTA solution from all the rabbits was used for the estimation of total erythrocyte count (TEC), total leukocyte count (TLC) and packed cell volume (PCV) by microhematocrit method (Jain 1986) and Hemoglobin (Hb) by Sahli’s method (Coles 1986). The blood smears were directly prepared and stained by Leishman’s stain for differential leukocyte count (DLC) by Battlement method (Jain 1986) and for description of morphological changes in the blood cells. Blood was collected from all rabbits into sterile test tube and allowed to clot. The serum was collected and stored at 4 °C and was used for the estimation of total serum proteins (Transia biochemical Ltd), glucose (M/S Excel Diagnostics Ltd), bilirubin (M/S Excel Diagnostics Ltd), BUN (M/S Excel Diagnostics Ltd), AST (M/S Excel Diagnostics Ltd), ALT (M/S Excel Diagnostics Ltd) and creatinine (Kamineni life Sciences Pvt Ltd) using kits.
Results
During early stage of infection, T. evansi infected rabbits showed clinical signs like varying degrees of emaciation, dehydration, mucopurulent nasal discharges and pasted perineum. Clinical signs such as roughened hair coat, more dulled appearance, recumbence and fluctuating pyrexia were noticed during third month of infection. Some animals were also showed the signs of corneal opacity and blindness, and these signs remained until the end of the experiment. Severe anaemia was the main haematological finding. The mean TEC, PCV, Hb and TLC values reduced significantly. In the acute phase, leukocytosis due to lymphocytosis followed by leukopenia during the chronic phase was recognized. Macrocytes, hypochromic cells, Howell-Jolly bodies, target cells, stomatocytes and burr cells are the main abnormalities observed in the erythrocytes. In addition to these changes anisocytosis, poikilocytosis and hypochromic RBC were also observed. Total serum proteins and glucose levels were decreased significantly (P < 0.01) and there was significant increase (P < 0.01) in cholesterol levels, bilirubin, creatinine, BUN, AST and ALT values. Mean haematological and biochemical values in rabbits of experimental groups were given in Tables 1 and 2.
Table 1.
Hematological values in the experimentally T. evansi infected and control group of rabbits
| Parameters | Control group of rabbits | Infected group of rabbits | t test | P value | |
|---|---|---|---|---|---|
| 30 days DPI | 60 days DPI | ||||
| TEC (106/mm3) | 3.95 ± 0.05 | 2.3 ± 0.16 | 1.2 ± 0.06 | 24.7** | 0.000 |
| Hb (g/dl) | 9.8 ± 0.10 | 5.25 ± 0.42 | 3.65 ± 0.09 | 39.3*** | 0.000 |
| PCV (%) | 37.0 ± 1.00 | 28 ± 0.76 | 19.50 ± 0.9 | 11.2*** | 0.000 |
| TLC (109/l) | 10.50 ± 0.5 | 13.5 ± 1.2 | 17.0 ± 0.5 | 7.08** | 0.002 |
| DLC | |||||
| Basophils (%) | 0 | 0 | 0 | ||
| Eosinophils (%) | 0 | 0 | 0 | ||
| Lymphocytes (%) | 61 ± 01 | 78 ± 1.59 | 90 ± 0.40 | 33.5*** | 0.000 |
| Monocytes (%) | 0 | 1 | 0 | ||
| Neutrophils (%) | 40.5 ± 0.5 | 21.17 ± 1.84 | 10.25 ± 0.47 | 38.7*** | 0.000 |
NS non significant (P > 0.05)
* Significant (P < 0.05); ** highly significant (P < 0.01)
Table 2.
Biochemical values in the experimentally T. evansi infected and control group of rabbits
| Parameters | Control group | Infected group | t test | P value | |
|---|---|---|---|---|---|
| 20 days DPI | 60 days DPI | ||||
| TSP (mg/dl) | 5.35 ± 0.05 | 2.32 ± 0.16 | 1.48 ± 0.1 | 24.7*** | 0.000 |
| Cholesterol (mg/dl) | 163.5 ± 1.5 | 183 ± 20.9 | 249 ± 5.5 | 10.2*** | 0.005 |
| Serum glucose (mg/dl) | 78 ± 2.0 | 70.3 ± 1.35 | 52.75 ± 1.1 | 12.2*** | 0.000 |
| Bilirubin (μg/dl) | 0.75 ± 0.02 | 0.89 ± 0.9 | 1.40 ± 0.14 | 3.0* | 0.036 |
| Creatinine (mg/l) | 2.1 ± 0.1 | 10.6 ± 0.34 | 16.5 ± 0.25 | 37.1*** | 0.000 |
| BUN (mg/dL) | 14.05 ± 0.4 | 17.5 ± 1.1 | 21.1 ± 1.3 | 3.3* | 0.027 |
| ALT (μl) | 47.8 ± 0.2 | 50.25 ± 1.9 | 63.38 ± 1.8 | 5.7** | 0.004 |
| AST (μl) | 22.5 ± 0.5 | 48 ± 1.59 | 71.7 ± 1.75 | 18.6*** | 0.000 |
NS non significant (P > 0.05)
* Significant (P < 0.05); ** highly significant (P < 0.01)
Discussion
The clinical signs observed in rabbits experimentally infected with T. evansi in the present study were in agreement with the reports of Chandra et al. (1999), Audu et al. (1999), Dargantes et al. (2005), Taiwo et al. (2003). Decreased values of TEC, Hb and PCV in the study might be due to increased susceptibility of red blood cell membrane to oxidative damage (Taiwo et al. 2003). Similar observations were made by Audu et al. (1999), Herrera et al. (2002), Hilali et al. (2006). In the present investigation, anaemia is the most consistent finding which is in accordance with Taiwo et al. (2003), Takeet and Fagbemi (2009). Morphological changes of erythrocytes observed in the study might be due to involvement of liver and the presence of burr cells was an indicator of renal failure (Abdul-majeed et al. 2007). Similar morphological changes were reported by Abdul-majeed et al. (2007), who observed the presence of anisocytosis, poikilocytosis, target cells, macrocytes, Howell-Jolly bodies, Burr cells and stomatocytes in rabbits experimentally infected with T. evansi Iraqi strain. The studies of Silva et al. (1999) and Ogunsanmi et al. (1994) supported our results and denoted that the presence of macrocytic hypochromic cells in the acute stage and normocytic hypochromic cells in chronic stage. Emeribe and Anosa (1991) stated that the macrocytic cells shifted terminally to microcytic hypochromic cells, with evidence of a moderate anisocytosis and poikilocytosis of erythrocytes.
In the acute phase, leukocytosis due to lymphocytosis followed by leukopenia during the chronic phase was recognized. These results were in consonance with the experiments of Emeribe and Anosa (1991), Onah et al. (1996), Silva et al. (1999), Hilali et al. (2006). Another experiment on goats opposed the mentioned results and stated that leukocytosis was not a reliable indicator of infection (Dargantes et al. (2005). In infected camels, Choudhary and Iqbal (2000) noted a significant decrease in lymphocyte with a visible increase in leukocytes and neutrophils. In other experimental infection of Norwegian lemmings with T. lemmi, the leukocyte counts remained the same (Wiqer 1978). The decrease in total serum protein level observed in this study is consistent with the findings of Sadique et al. (2001) who reported decreased in total protein in cattle infected with T. congolense. The results contradicts the observations made in sheep infected with T. brucei by Taiwo et al. (2003), who observed no change in the levels of total plasma proteins from pre-infected values at the initial stage of the infection, but in the later stage the levels increased significantly above pre-infection levels. Protein levels usually drop in trypanosome infections as a result of depressed albumin levels. The increase in protein levels during the chronic phase of the infection is usually due to the increase in globulin levels. This is as a result of the immune response by the animals to the T. evansi infection (Lushaikyaa et al. 2011).
In the present study, increase in cholesterol levels agrees with the finding of Diehl and Risby (1974), Abenga and Anosa (2007) who also reported increase in cholesterol levels in T. brucei gambiense infected rabbits and vervet monkey, respectively. In contrast, decreased cholesterol levels were reported by Robert and Clarkson (1977), Adamu et al. (2008). Hypercholesterolemia has been associated with hepatic malfunction resulting from impairment of liver lipid metabolism (Adejinmi and Akinboade 2000). The result of hypoglycemia is in consonance with the findings of Takeet and FagbemI (2009), Taiwo et al. (2003). Hypoglycaemia has been reported in natural trypanosomosis in human and animals (Moon et al. 1968; Wellde et al. 1974). Excessive utilization of the blood glucose by trypanosomes for their metabolism has been thought to account for the hypoglycaemia observed during trypanosomosis (Anosa 1988).
The increased levels of total plasma bilirubin in the present experiment support the earlier observations of Gow et al. (2007) who observed in dogs naturally infected with T.congolense had elevated level of bilirubin. The increase in bilirubin in rabbits is suggestive of haemolytic anaemia due to. T. congolense (Takeet and Fagbemi 2009) or obstructive jaundice as previously reported in T. brucei infected rabbits (Arowolo et al. 1988). In the present study raised levels of serum creatinine were in accordance with the findings of Adejinmi and Akinboade (2000). This was associated with damage to host tissues as well as renal and hepatic malfunction (Abenga and Anosa 2005). Elevation in the BUN level in the present study is in consonance with the observation reported by Adejinmi and Akinboade (2000), Abenga et al. (2002), Abenga and Anosa (2007). The elevated levels of ALT and AST enzymes are in agreement with earlier reports of Taiwo et al. (2003), Adah et al.(1992), Omotainse et al. (1994) in various trypanosome-infected animals. The elevated values of ALT and AST enzymes may be due to tissue breakdown (necrosis) and inflammation in the host, particularly of the liver, heart, muscle and kidney (Taiwo et al. 2003; Takeet and Fagbemi 2009). Another possibility of increased levels of ALT and AST enzymes is the lysed trypanosomes (Taiwo et al. 2003; Takeet and Fagbemi 2009) at different stages of the infection (Figs. 1, 2, 3).
Fig. 1.
Blood film (a) macrocyte, (b) hypochromic RBC, (c) burr cell, (d) stomatocyte
Fig. 2.

Blood film (a) Howell-Jolly bodies
Fig. 3.
Blood film (a) target cell
References
- Abdul-majeed HA, Abbas FH, Abbood HF. Blood picture and hepatic changes in rabbits experimentally infected with Trypanosoma evansi. Iraqi strain. Med J of Babylon. 2007;4(3–4):358–364. [Google Scholar]
- Abenga JN, Anosa VO. Serum total proteins and creatinine levels in experimental gambian trypanosomiasis of vervet monkeys. Afr J Biotechnol. 2005;4(2):187–190. [Google Scholar]
- Abenga S, Anosa VO. Serum biochemical changes in experimental Gambian trypanosomiasis II. Assessing hepatic and renal dysfunction. Turk J Vet Anim Sci. 2007;31(5):293–296. [Google Scholar]
- Abenga JN, Sanda SA, Idowu TB, Lawani FAG. Effect of acute caprine trypanosomiasis on haemoglobin, urea and serum electrolytes. Afr J Clin Exp Microbiol. 2002;3:45–47. [Google Scholar]
- Adah MJ, Otesile EB, Joshua RA. Changes in level of transaminases in goats experimentally infected with Trypanosoma congolense. Rev Elev Med Vet Pays Trop. 1992;45(3–4):284–286. [PubMed] [Google Scholar]
- Adamu S, Ige AA, Jatau ID, Neils JS, Useh NM, Bisalla M, Ibrahim NDG, Nok AJ, Esievo KAN. Changes in the serum profiles of lipids and cholesterol in sheep experimental model of acute African trypanosomosis. Afr J Biotechnol. 2008;7(12):2090–2098. [Google Scholar]
- Adejinmi JO, Akinboade OA. Serum biochemical changes in WAD goats with experimental mixed T. brucei and Cowdriaruminantium infections. Trop Vet. 2000;18(1–2):111–120. [Google Scholar]
- Allam L, Ogwu D, Agbede RIS, Anthony Hematological and serum biochemical changes in gilts experimentally infected with Trypanosoma brucei. Vet Arhiv. 2011;81(5):597–609. [Google Scholar]
- Anosa VO. Haematological; and biochemical changes in human and animal trypanosomosis. Part II. Rev Elev Med Vet Pays Trop. 1988;4(2):151–164. [PubMed] [Google Scholar]
- Arowolo RO, El-hassan EO, Omure BO. Assessing hepatic dysfunction in rabbits experimentally infected with Trypanosoma brucei. Rev Elev Med Vet Pays Trop. 1988;4:277–281. [PubMed] [Google Scholar]
- Audu PA, Esievo KA, Mohammed G, Ajanusi OJ. Studies of Infectivity and pathogenicity of an isolate of Trypanosoma evansi in Yankasa sheep. Vet Parasitol. 1999;86(30):185–190. doi: 10.1016/S0304-4017(99)00141-7. [DOI] [PubMed] [Google Scholar]
- Chandra D, Tripathi BN, Srivastava RVN, Singh R. Pathological experimental Trypanosoma evansi infection in rabbits. Indian J Vet Pathol. 1999;23:44–46. [Google Scholar]
- Choudhary ZI, Iqbal J. Incidence, biochemical, and hematological alterations induced by natural trypanosomosis in racing dromedary camels. Acta Trop. 2000;77(2):209–213. doi: 10.1016/S0001-706X(00)00142-X. [DOI] [PubMed] [Google Scholar]
- Coles EH. Veterinary clinical pathology. 6. Philadelphia: W B Saunders Co.; 1986. pp. 243–255. [Google Scholar]
- Dargantes AP, Reid SA, Copman DB. Experimental Trypanosoma evansi infection in the goat. I. Clinical signs and clinical pathology. J Comp Pathol. 2005;133(4):261–266. doi: 10.1016/j.jcpa.2005.06.001. [DOI] [PubMed] [Google Scholar]
- Diehl EJ, Risby EL. Serum changes in rabbits experimentally infected with Trypanosoma gambiense. Am J Med Sci. 1974;23(6):19–22. doi: 10.4269/ajtmh.1974.23.1019. [DOI] [PubMed] [Google Scholar]
- Emeribe AO, Anosa VO. Haematology of experimental Trypanosoma brucei gambiense. II. Erythrocyte and leukocyte changes. Rev Elev Med Vet Pays Trop. 1991;44:53–57. [PubMed] [Google Scholar]
- Gow AG, Simpson JW, Picozzi K. First report of canine Africa trypanosomosis in the UK. J Small Anim Pract. 2007;48:658–661. doi: 10.1111/j.1748-5827.2007.00423.x. [DOI] [PubMed] [Google Scholar]
- Herrera HM, Alessi AC, Marques LC, Santana AE, Aquino LP, Menezes RE, Moraes MA, Machado RZ. Experimental Trypanosoma evansi infection in South American coati (Nasua nasua): hematological, biochemical and histopathological changes. Acta Trop. 2002;81(3):1–203. doi: 10.1016/S0001-706X(01)00204-2. [DOI] [PubMed] [Google Scholar]
- Hilali M, Abdel-Gawad A, Nassar A, Abdel-Wahab A. Hematology and biochemical changes in water buffalo calves. Vet Parasitol. 2006;139(1–3):237–243. doi: 10.1016/j.vetpar.2006.02.013. [DOI] [PubMed] [Google Scholar]
- Jain NC. Schalm’s veterinary haematology. 4. Philadelphia: Lea and Fediger Comp; 1986. [Google Scholar]
- Moon AP, Williams JS, Witherspoon C. Serum biochemical changes in mice infected with T. rhodesiense and T. duttoni. Exp Parastol. 1968;22:112–121. doi: 10.1016/0014-4894(68)90084-2. [DOI] [PubMed] [Google Scholar]
- Ogunsanmi AO, Akpavie SO, Anosa VO. Hematological changes in ewes experimentally infected with Trpanosoma brucei. Rev Elev Med Vet Pays Trop. 1994;47(1):53–57. [PubMed] [Google Scholar]
- Omotainse SO, Anosa VO, Falaye C. Clinical and biochemical changes in experimental Trypanosoma brucei infection of dogs. Israel J Vet Med. 1994;49:36–39. [Google Scholar]
- Onah DN, Hopkins J, Luckins AG. Hematological changes in sheep experimentally infected with T. evansi. Parasitol Res. 1996;82(8):659–663. doi: 10.1007/s004360050181. [DOI] [PubMed] [Google Scholar]
- Robert CJ, Clarkson MJ. Free fatty acids, lysophosphatidylcholine and pathogenesis of trypanosomiasis. Lancet. 1977;1:952–953. doi: 10.1016/S0140-6736(77)92246-2. [DOI] [PubMed] [Google Scholar]
- Sadique NA, Adejinmi JO, Ariri H. Haematological and plasma protein values of Zebu cattle in trypanosome-endemic zone. Trop Anim Prod Invest. 2001;4:219–223. [Google Scholar]
- Silva RA, Ramirez L, Souza SS, Ortiz AG, Pereira SR, Davila AM. Hematology of natural bovine trypanosomosis in the Brazilian Pantanal and Bolivian WETLANDS. Vet Parasitol. 1999;85(1):87–93. doi: 10.1016/S0304-4017(99)00081-3. [DOI] [PubMed] [Google Scholar]
- Taiwo VO, Olaniyi MO, Ogunsanmi AO. Comparative plasma biochemical changes and susceptibility of erythrocytes to in vitro peroxidation during experimental Trypanosoma congolense and Trypanosoma brucei infection in sheep. Israel J Vet Med. 2003;58(4):30–33. [Google Scholar]
- Takeet M, Fagbemi BO. Haematological, pathological and plasma biochemical changes in rabbits experimentally infected with Trypanosoma congolense. Sci World J. 2009;4(2):29–36. [Google Scholar]
- Wellde BT, Lotzsch R, Diehl G, Sadun E, Williams J, Warui G. Trypanosoma congolense. I. Clin Parasitol. 1974;36:6–19. doi: 10.1016/0014-4894(74)90107-6. [DOI] [PubMed] [Google Scholar]
- Wiqer R. Hematological, splenic, and adrenal changes associated with natural and experimental infections of Trypanosoma lemmi in Norwegian lemming, Lemmus lemmus (L) Follia Oarasitol (Praha) 1978;25(4):295–301. [PubMed] [Google Scholar]
